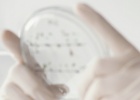

Intervenções

A habitação não pode ser vista como mercadoria
10 Março 2026
Senhora Deputada Isilda Gomes, fez aqui uma parte exacta do diagnóstico do problema da habitação, um pouco por toda a União Europeia, incluindo Portugal.

Regime de insolvência – a prioridade é defender a actividade produtiva e os direitos dos trabalhadores
9 Março 2026
Senhor Presidente, Senhor Comissário McGrath, numa situação de insolvência a prioridade deve ser a manutenção da atividade produtiva, a preservação dos postos de trabalho e dos direitos dos trabalhadores.

Desigualdade entre mulheres e homens - não chega o diagnóstico, precisamos de políticas alternativas
9 Março 2026
Senhor Presidente, Senhor Comissário McGrath, as desigualdades entre mulheres e homens são uma das mais evidentes demonstrações das desigualdades que caracterizam o sistema económico em que vivemos.

O pacote laboral agrava a desigualdade entre mulheres e homens
9 Março 2026
Senhor Deputado Paulo Nascimento Cabral, a pergunta que lhe quero fazer é: como é que compatibiliza o discurso sobre a igualdade entre mulheres e homens com a política que está a fazer o Governo português que o senhor apoia, particularmente com a proposta de pacote laboral?

Os problemas das mulheres não são triviais – como diz a extrema-direita
9 Março 2026
Senhora Presidente, Senhora Deputada Latinopoulou, se compreendi bem, a senhora deputada entende que nós estamos hoje aqui a discutir questões triviais.
Ciência tem de ser sinónimo de progresso, coesão e direitos sociais
9 Março 2026
Senhora Presidente, Senhora Comissária Zaharieva, o progresso científico e tecnológico não pode ser espartilhado na lógica da política da competitividade em função dos objetivos de acumulação de lucro dos grandes grupos económicos e financeiros.

Sobre os riscos da chamada “União de Poupanças e Investimentos” para os sistemas públicos de Segurança Social
9 Março 2026
A intenção da Comissão Europeia avançar com a designada “União de Poupanças e Investimentos” suscita sérias preocupações pela ameaça que constitui à sustentabilidade dos sistemas públicos de segurança social nos Estados-Membros e aos direitos sociais dos trabalhadores, bem como pelos seus previsíveis impactos negativos na estabilidade financeira e na gestão prudencial do risco.

Contra o Pacote Laboral, pelos direitos dos trabalhadores - tomamos iniciativa no Parlamento Europeu
9 Março 2026

Impactos das tempestades reclamam necessidade urgente de apoios da UE à pesca artesanal e costeira em Portugal
18 Fevereiro 2026
O sector da pesca está a ser profundamente afectado com a sucessão de tempestades que assolaram Portugal.
Num sector já a braços com múltiplos problemas, praticamente desde o princípio do ano que os pescadores se vêem impedidos de ir ao mar. A situação é dramática, atingindo milhares de pessoas e havendo já relatos de famílias a passar fome.

Aumento do custo de vida e desigualdades económicas e sociais - precisamos de políticas de aumento dos salários e controlo de preços
12 Fevereiro 2026
Senhora Comissária Kos, a situação que vivemos é, de facto, uma situação de agudização das desigualdades económicas e sociais no espaço da União Europeia, com o crescimento económico a ser acompanhado da concentração da riqueza. Ao contrário daquilo que nos dizem os dogmas liberais, não basta criar mais riqueza para ultrapassar o problema das desigualdades. É preciso que a riqueza seja distribuída com mais justiça.
- « primeira
- ‹ anterior
- 1
- 2
- 3
- 4
- 5
- 6
- 7
- 8
- 9
- …
- seguinte ›
- última »